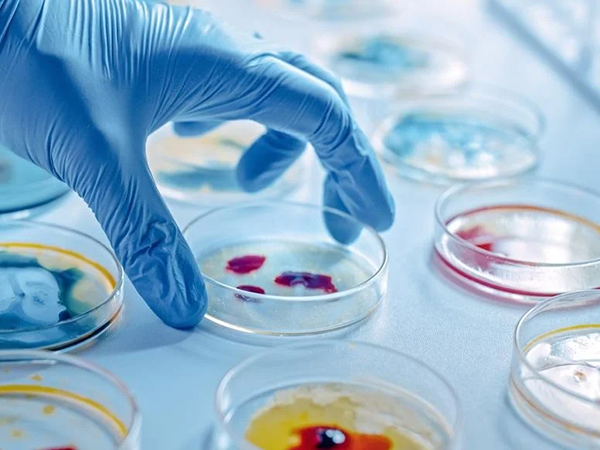

About Us
About Us
AfBSA is a non-governmental, non-political, non-sectarian and non-profit making association through which its members work, co-operate and collaborate with one or each other, or with other associations, scientific or health organizations, institutions or individuals throughout Africa or elsewhere in the world to promote Biosafety and Biosecurity as scientific disciplines in Africa.
The Association is continental, having its primary area of operation within the Continent of Africa and whose membership is primarily drawn from persons and institutions of Africa as hereinafter provided.
The Association has its headquarters in Nairobi, Kenya. The Association is organized exclusively for such purposes as are authorized and permitted by the Laws of Kenya. In future the Association may open and maintain an office or create an agency in any country in Africa or otherwise to enable it serve its members efficiently or so as to achieve any or all of its objectives and notwithstanding anything herein provided, such office or agency shall be subject to the laws of the country wherein it is situated in addition to the general direction from the head office in Nairobi in the Republic of Kenya.
The Council is the governing body of the Association supported by elected officers through standing and ad hoc committees, according to the Bylaws of the Association. The day to day operations of the Association is conducted by the Officers of the Association who include the President, Chief Executive Officer, a Secretary, and a Treasurer. The board of directors includes the President, The Treasurer, and the Secretary.
Membership to the Association includes Individual Members, Corporate Members, Student Members, Emeritus Members and Honorary Members.
